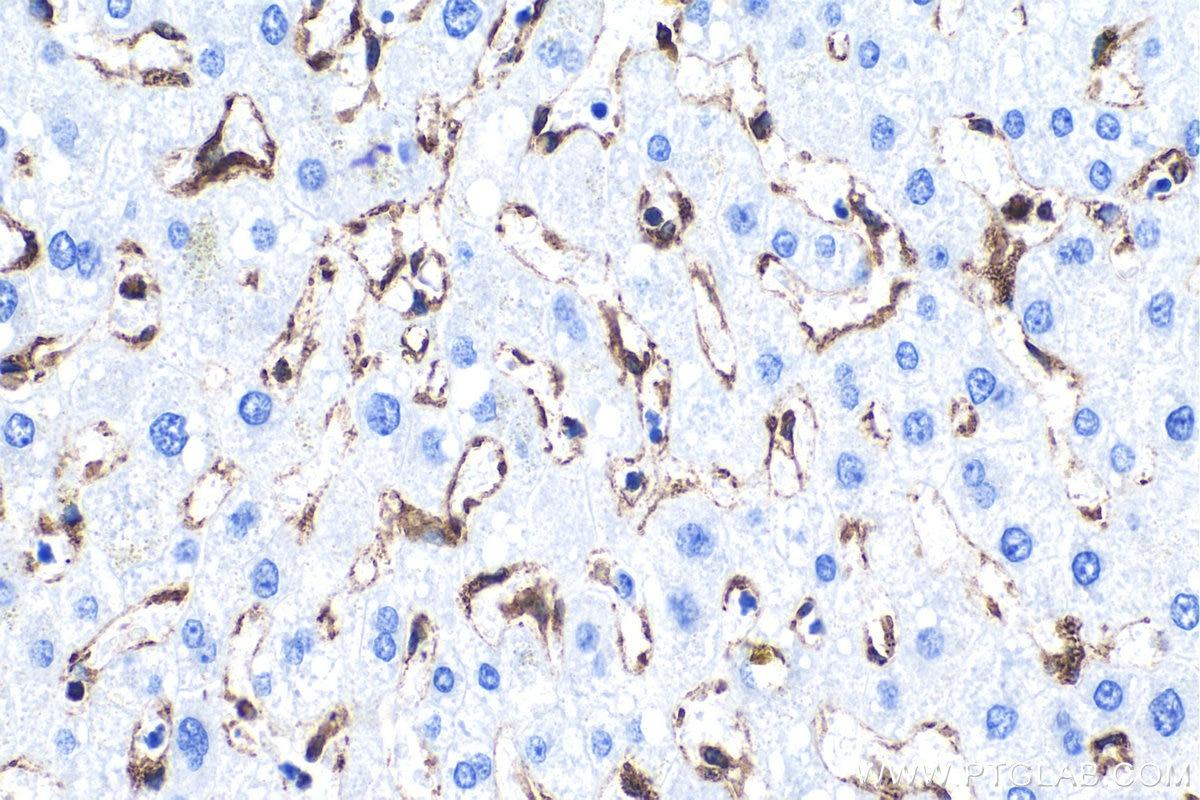

■ Multi-rAb(マルチ・ラブ)とは?
カクテルタイプの新しい二次抗体
『Multi-rAb(マルチ・ラブ)』は、複数クローンのリコンビナント(組換え)抗体を混合したカクテルタイプの二次抗体です。Multi-rAbに含まれる各クローンは、プロテインテックラボにおける厳格なスクリーニング戦略を介して取得され、厳密な特性解析によって選抜されました。各クローンは同一の免疫グロブリン(IgG)上に位置する重複しないエピトープを正確かつ高感度に認識します。ウェスタンブロット(WB)等のアプリケーション検証と最適化によって、カクテル化する複数クローンの組み合わせのパターンが選択/決定され、最高水準のパフォーマンスを発揮する『新タイプの二次抗体』は完成しました。

図1. 『Multi-rAb(マルチ・ラブ)』の開発プロセス
■ 免疫組織化学(IHC)で使用されるポリマー試薬とは?
免疫組織化学(IHC)とは
免疫組織化学(IHC)とは、組織中の抗原分子(主にタンパク質)に対して特異的な抗体を用いて、抗原抗体反応により標的とする抗原分子/タンパク質の存在有無、発現量または局在を明らかにするための実験手法です。
免疫組織化学(IHC)における検出方法とは?
ガラススライドに貼り付けた組織切片上の抗原分子/タンパク質に結合した抗体は、一般的に「酵素抗体法」を用いて検出されます。酵素抗体法は、酵素活性を利用した基質の発色を検出原理とする方法です。その際、一次抗体を酵素で直接標識する方法(「直接法」)および酵素標識二次抗体を用いて一次抗体を間接的に標識する方法(「間接法」)があり、後者では感度の向上等の利点があります。検出感度をさらに向上させるために「ABC法(avidin-biotin complex method、アビジン-ビオチン複合体法)」や「LSAB法(labeled streptavidin-biotin method、標識ストレプトアビジン-ビオチン法)」等の多くの手法が開発されています[DOI:10.5772/intechopen.82072  ]。
]。
その中で「ポリマー法(高分子ポリマー法)」は、現在主流となっている代表的なIHC検出手法の1つです。本手法では、鎖状のポリマー骨格に結合した二次抗体と酵素からなる検出試薬(ポリマー試薬)が利用されます。ポリマー骨格に結合した二次抗体と多数の酵素分子が利用されるため、検出感度は大きく向上します(図2)。またポリマー法では、ABC法やLSAB法で問題になる可能性がある内因性ビオチンに対する非特異的(擬陽性)反応はありません。そのため、ポリマー法は、高感度かつ低バックグラウンドのIHC検出を実現します[PMID:30539453  、27809448
、27809448  ]。
]。

図2. 一般的なポリマー試薬の模式図
■ Multi-rAb(マルチ・ラブ)ポリマー試薬の利点
高いロット間一貫性
『Multi-rAb(マルチ・ラブ)』は「リコンビナント(組換え)モノクローナル抗体」を混合して製造されます。遺伝子配列を取得して作製されたリコンビナント抗体発現用の各クローンは、同質かつ均一な抗体群を産生するため、高いロット間一貫性と安定的な供給能を提供します。ロット間変動を最小限に抑えられるため、研究結果の一貫性/再現性が重要となる長期的プロジェクトにおいても有用です。
最小限の種間交差反応性
二次抗体の非特異的な交差反応性は二次抗体が本来標的としていない免疫グロブリン(Ig)と結合することで生じます。組織中の内在性の免疫グロブリン(Ig)や、マルチプレックス(多重)染色で併用される複数の動物種由来/アイソタイプの一次抗体に対して非特異的に結合した場合、高いバックグラウンドにつながります。『Multi-rAb(マルチ・ラブ)』の開発プロセスでは、ターゲット動物種以外のIgGへの交差反応性が最小限のクローンをスクリーニングし、厳選されたクローンから発現させたリコンビナントモノクローナル抗体を混合しています。以下のデータが示す通り、交差吸着処理済みポリクローナル二次抗体と同等以上の高い種特異性と低いバックグラウンドを実現します。

図3. Multi-rAb(マルチ・ラブ)抗ウサギIgG製品と競合他社製品(交差吸着処理済み製品/未処理製品)を用いた各動物種IgGに対する交差反応性の比較。























 このページを印刷する
このページを印刷する